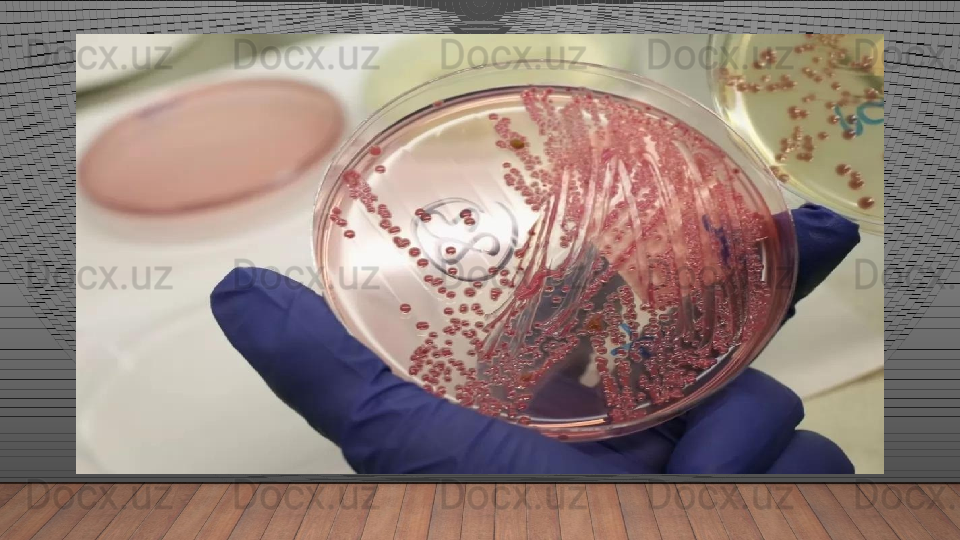

Дата регистрации 10 Май 2023
5700 ПродажOziq-ovqat mahsulotlari kasalliklari

Oziq-ovqat mahsulotlari kasalliklari